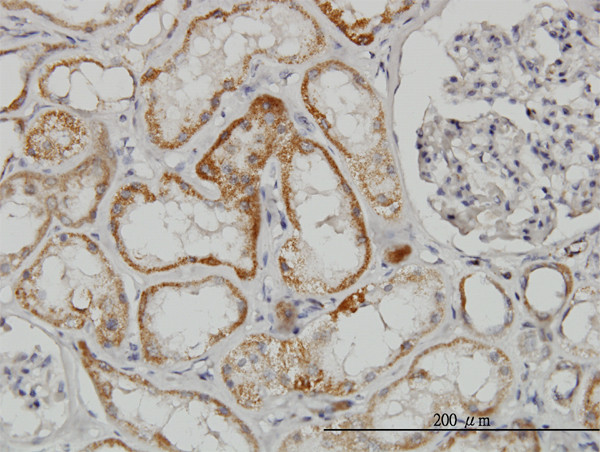
TAOK2 Antibody in Immunohistochemistry (Paraffin) (IHC (P))

Search
Abnova
TAOK2 Monoclonal Antibody (2E2)
{{$productOrderCtrl.translations['antibody.pdp.commerceCard.promotion.promotions']}}
{{$productOrderCtrl.translations['antibody.pdp.commerceCard.promotion.viewpromo']}}
{{$productOrderCtrl.translations['antibody.pdp.commerceCard.promotion.promocode']}}: {{promo.promoCode}} {{promo.promoTitle}} {{promo.promoDescription}}. {{$productOrderCtrl.translations['antibody.pdp.commerceCard.promotion.learnmore']}}
产品信息
H00009344-M03
宿主/亚型
分类
类型
克隆号
抗原
偶联物
形式
浓度
规格
保存条件
运输条件
产品详细信息
Sequence of this protein is as follows: ELQCRQYKRK MLLARHSLDQ DLLREDLNKK QTQKDLECAL LLRQHEATRE LELRQLQAVQ RTRAELTRLQ HQTELGNQLE YNKRREQELR QKHAAQVRQQ
靶标信息
TAOK2 (TAO1) is a serine/threonine kinase that may be an important regulator of the stress-responsive p38 MAP kinase pathway. In vitro, TAO (thousand and one amino acid) protein kinase 2 (TAO2) activates MAP/ERK kinases (MEK ) 3, 4, and 6 toward their substrates p38 MAP kinase JNK/SAPK (Chen et al., 1999; Chen and Cobb, 2001). This and more recent work has led to the proposal that the TAO protein kinases play an essential role in signaling from physiological agonist to the stress -responsive p38 MAPK (Chen et al., 2003). Autophosphorylation of TAO may play a role in the mechanism of TAO activation. The MEK binding domain of TAO is autophosphorylated on both serine and threonine residues and Ser181 is located within this domain.
仅用于科研。不用于诊断过程。未经明确授权不得转售。